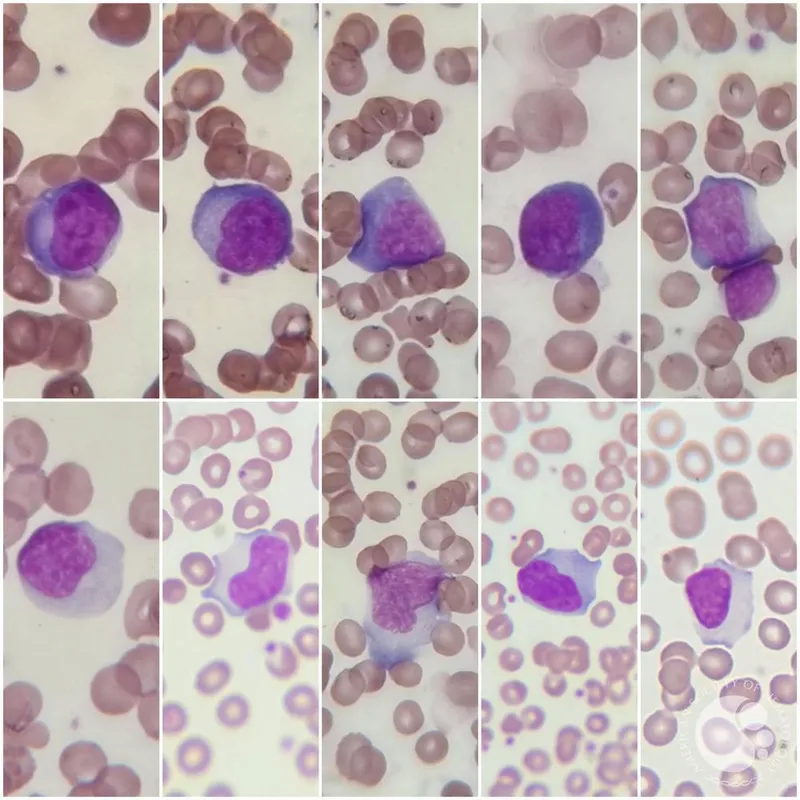
Atypical lymphocytes (Downey cells) in peripheral smear

WBC Overview - Count Control
-
WBC production (leukopoiesis) regulated by growth factors (e.g., G-CSF) & cytokines, responding to stimuli (infection).
-
Normal WBC Counts & Differentials (Approximate Ranges in Children):
Age Total WBC (x10³/µL) Neutrophils (%) Lymphocytes (%) Newborn 9-30 40-80 20-40 1-12 mo 6-17.5 20-45 45-70 1-6 yr 5-15.5 25-60 35-65 >6 yr 4.5-13.5 35-70 25-50 -
Key Definitions: (ANC: Absolute Neutrophil Count)
- Leukocytosis: ↑ WBC count (age-specific).
- Leukopenia: ↓ WBC count (age-specific).
- Neutrophilia: ↑ ANC (age-specific).
- Neutropenia: ANC < 1500/µL (Mild: 1000-1500; Moderate: 500-999; Severe: < 500/µL).
- Lymphocytosis: ↑ Lymphocytes (age-specific).
- Lymphopenia: ↓ Lymphocytes (age-specific).
- Eosinophilia: Eosinophils > 500/µL.
⭐ Age-related variations in WBC counts are crucial; lymphocyte predominance is normal in early childhood (up to 4-6 years), shifting to neutrophil predominance later.

Neutrophil Disorders - Neutro-Navigators
- Neutropenia: Absolute Neutrophil Count (ANC) < 1500/µL; severe if ANC < 500/µL.
- Causes: Congenital (e.g., Kostmann syndrome, cyclic neutropenia); acquired (e.g., drugs, infections, autoimmune).
- Neutrophilia: Increased neutrophils.
- Causes: Infections, inflammation, stress.
- Functional Neutrophil Disorders:
- Chronic Granulomatous Disease (CGD): Defect in NADPH oxidase. Recurrent infections with catalase-positive organisms (📌 e.g., S. aureus, Aspergillus, Serratia). Diagnosis: Dihydrorhodamine (DHR) test or Nitroblue Tetrazolium (NBT) test.
- Leukocyte Adhesion Deficiency (LAD): Types I, II, III. Delayed umbilical cord separation, recurrent non-purulent bacterial infections.
⭐ Chronic Granulomatous Disease (CGD) is most commonly X-linked recessive and diagnosed by an abnormal dihydrorhodamine (DHR) flow cytometry test or nitroblue tetrazolium (NBT) dye test, showing impaired phagocytic oxidative burst.

Lymphocyte Disorders - Lympho-Legends
- Lymphocytosis: ↑ Lymphocytes
- Definition: Age-dependent. Infants >9000/µL, older children >7000/µL.
- Causes:
- Viral: Infectious Mononucleosis (EBV, CMV) - Downey cells (atypical lymphocytes).
- Bacterial: Pertussis (marked ↑, normal morphology), TB.
- Malignancies: Acute Lymphoblastic Leukemia (ALL).
- Lymphopenia: ↓ Lymphocytes
- Definition: Age-dependent. Older children <1500/µL.
- Causes: Immunodeficiencies (SCID, DiGeorge), HIV, drugs, malnutrition.
- Severe Combined Immunodeficiency (SCID):
- Presentation: Failure to thrive (FTT), recurrent severe infections, absent thymic shadow.
- Key Types: X-linked, ADA deficiency.
⭐ Infectious Mononucleosis (caused by EBV) is characterized by fever, pharyngitis, posterior cervical lymphadenopathy, splenomegaly, and atypical T lymphocytes (Downey cells) on the peripheral blood smear.
Eosinophil & Other Disorders - Eosino-Enigmas
- Eosinophilia: Absolute eosinophil count >500/µL.
- Causes 📌 NAACP: Neoplasm, Allergy/Asthma, Addison's disease, Collagen vascular diseases, Parasitic infections.
- Hypereosinophilic Syndrome (HES): Persistent eosinophilia >1500/µL with end-organ damage.

- Monocyte Disorders:
- Monocytosis: ↑ monocytes. Causes: Chronic infections (e.g., TB), IBD, malignancies.
- Langerhans Cell Histiocytosis (LCH): Rare, clonal proliferation of Langerhans cells; can affect bone, skin.
- Basophil Disorders:
- Basophilia: ↑ basophils. Rare. Causes: CML, allergic reactions, hypothyroidism.
⭐ The mnemonic 'NAACP' (Neoplasm, Allergy/Asthma, Addison's disease, Collagen vascular diseases, Parasites) is a useful tool for remembering the common causes of eosinophilia in children.
High‑Yield Points - ⚡ Biggest Takeaways
- Neutropenia: ANC < 1500/µL (severe < 500/µL). Kostmann syndrome (SCN) ↑ AML risk.
- LAD-1: CD18 defect, delayed cord separation, recurrent non-purulent infections, marked neutrophilia.
- Chédiak-Higashi: AR; partial albinism, recurrent infections, giant granules in WBCs.
- CGD: Defective NADPH oxidase, recurrent catalase-positive infections. DHR/NBT test.
- EBV (Mononucleosis): Fever, pharyngitis, lymphadenopathy, atypical lymphocytes (Downey cells).
- ALL: Most common childhood cancer; lymphoblasts in blood/marrow, pancytopenia.
Unlock the full lesson and continue reading
Signup to continue reading this lesson and unlimited access questions, flashcards, AI notes, and more